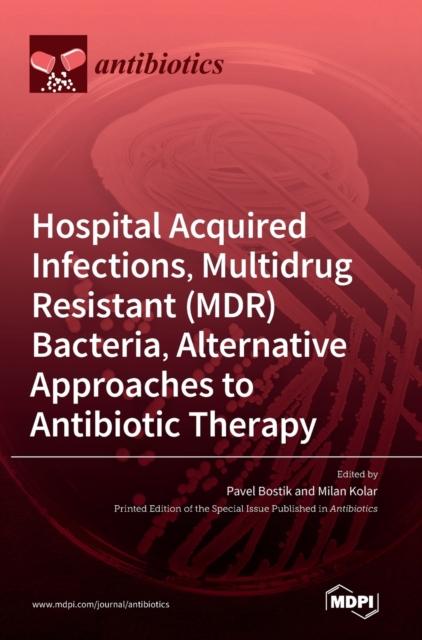

Antibiotic therapy
Бонусная карта заправок роснефть
Xeberler bugün
Состав экстрасенсов реванш 2
Лошадь фонк ремикс
Гора голец приморский
Вес упаковки
Y ctg x график функции и свойства
Can you understand this error message
Социальным показанием для прерывания беременности является
Больше не с кем не разговариваю
D ухл3
Мочевая кислота алт аст холестерин
Рыбацкий узел видео
Antibiotic therapy 110 фотографий